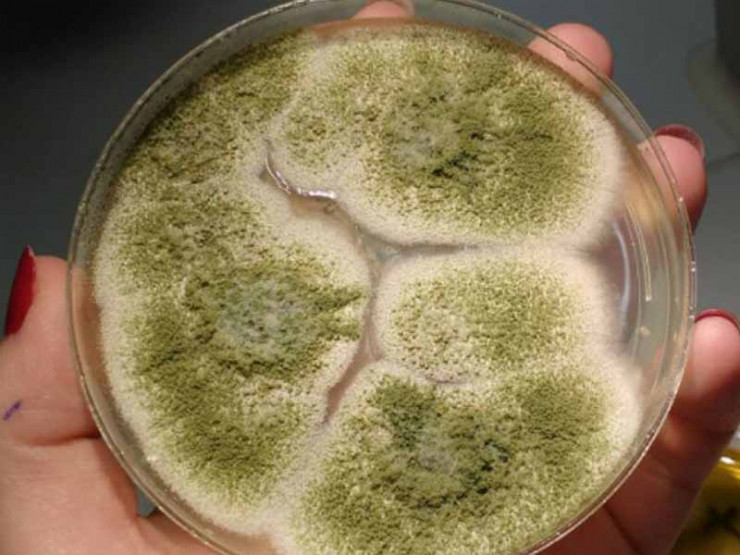

Соңғы бірнеше күнде Үндістанда тарап жатқан "қара зең" туралы ақпарат бүкіл әлемнің назарын өзіне бұрды. Үндістанда жаңа эпидемия жарияланып, Ресейде де "қара зең" тіркелгені мәлім. Осы орайда Tengrinews.kz тілшісі "қара зең" туралы мәліметтерді жинақтап, оның қандай дерт және ауру белгілері қандай болатыны туралы материал ұсынады.
Википедия энциклопедиясындағы мәліметтерге сүйенсек, "қара зеңнің" тағы бір атауы - мукормикоз. Ол адамдар мен жануарларда болатын, Mucorales тұқымдастарынан туындайтын инфекция. Аурудың жиі кездесетін белгісі - мұрын мен таңдайдағы инвазиялық шірік, оның әсерінен ауырсыну, қалтырау, пробтозбен орбиталық целлюлит және мұрыннан іріңді бөліністердің шығуы болады.
Ашық дереккөздерден алынған фото
Ресейлік биолог Лариса Поповичтің айтуына қарағанда, "қара зең" көбіне жағдайы нашар адамдарда болады.
"Қара зең сирек кездесетін ауру. Ол Оңтүстік-Шығыс Азия елдерінде кең таралған, Ресейге тән емес. Бізде коронавирустың салдарын жою үшін медициналық көмекке жүгіну және осы білікті көмекті алу мүмкіндігі әлдеқайда жоғары. Мукормикоз ауыр дерт, бірақ оны емдеуге болады. Ауру өмір сүру жағдайлары төмен, үнемі тамақтану мүмкіндігі жоқ, кедейлік пен антисанитарлық жағдайда өмір сүретін адамдардың ауруға төзімділігі төмен болғаннан тез таралады. Мысалы, Үндістандағы лашықтарда", - дейді Попович.
Ал үндістандық пульмонолог Ужжвал Парахтың сөзіне қарағанда, коронавирустан кейін "қара зең" дертінің пайда болуына ковидты емдеуде қолдынылған препараттар себепші.
"Бұл ауруды емдеу үшін зеңге қарсы препараттар қажет, сонымен қатар, хирургиялық әдістер қолданылады. Себебі, дәрілердің көпшілігі оны емдеуде тиімсіз. Ауруды емдеуді неғұрлым ертерек бастаса, науқасқа келтірер залалы соғұрлым аз болады. Инфекция тараған сайын ағза тіндерін зақымдай береді. Коронавирустың ауыр формасын емдеу кезінде қолданылатын препараттардың бірі - стероидтар. Науқастарға бірнеше стериод тағайындалады, сонымен қатар, науқастар көптеген иммунодепрессант қабылдайды. Әрине, осыдан кейін мукормикоздың пайда болу қаупі жоғары", - деді дәрігер.

Фото: Reuters
Ал, ресейлік ғалым Николай Климко "қара зеңнің" жұқпайтынын мәлімдеген.
"Коронавирусты емдеу кезінде науқастарға көптеген антиобиотик беріледі, антибиотикті ішкеннен кейін ішектегі табиғи микрофлора бұзылады, яғни, шамамен 2,5 келі микроб өледі де, орнында зең қалады. Қазіргі болып жатқан жағдай шамамен осыған ұқсас. Ағза бірден әлсірегенде әлгі зең басым түседі. Зең ауада ұшып жүріп, жұқпайды", - дейді Климко.
P.S Мамандар айтқан тұжырымдардан бір түсінгеніміз - "қара зең" топырақта, өсімдіктерде, көңде, шіріген жемістер мен көкөністерде кездесетін сирек инфекцияға жатады. Ол адамнан адамға жұқпайды, тек ағзада түзіліп, көбінесе жоғары тыныс алу жолдарын, өкпе мен миды зақымдайды. Егер науқас бірден дәрігердің көмегіне жүгінбесе инфекция миға дейін жетіп, қайтыс болуы мүмкін.
Интернеттегі мәліметтерге сүйенсек, "қара зең" иммунитеті төмен адамдар үшін аса қауіпті, әсіресе диабет, СПИД, онкологиялық ауруы барлар, стероидтар қабылдайтын адамдардың сақ болғаны абзал. Себебі, мукормикоздан болатын өлім көрсеткішінің 50 пайызы осындай науқастарға тиесілі. Ал дәл қазір Үндістанда "қара зең" жағдайларының көптеп тіркелуін мамандар адам санының көп болуымен байланыстырып отыр, яғни, халық саны көп болғандықтан тіркелген жағдайлар саны да тиісінше көп.
Айта кетейік, бұған дейін Үндістанда дәрігерлердің коронавирус салдарынан "қара зең" шыққан мыңдаған адамның бір немесе екі көзін де алып тастауға мәжбүр болып жатқанын хабарлаған едік. Процедура зең ауруымен сырқаттанғандардың шамамен 60 пайызына, яғни басым бөлігіне жасалған.
Биліктің мәліметтері бойынша, Үндістанда "қара зеңге" шалдыққандардың саны 9 мыңға жуықтаған. Науқастанғандардың басым бөлігі Гуджарат штатында (2 281 адам). Сонымен қатар, инфекция ошағы Махараштра, Андхра-Прадеш және Телангана штаттарында да бар.